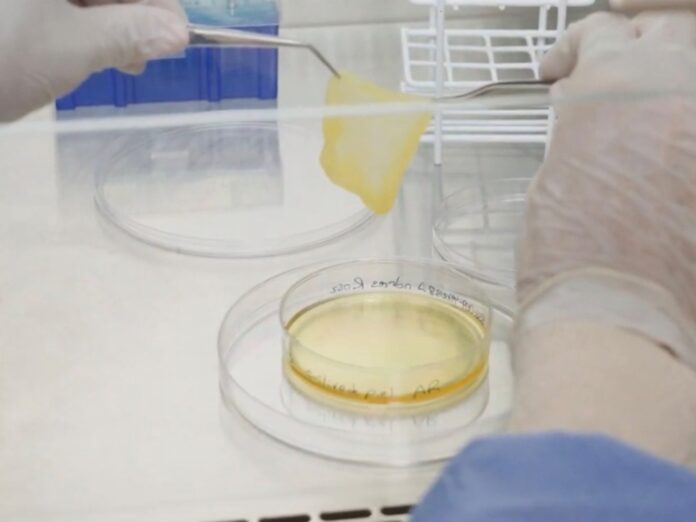

Avance Médico en Argentina: Un Paciente Recupera su Piel Tras Terribles Quemaduras
Un hombre de 46 años hace historia al ser el primer paciente en regenerar su propia piel en un brazo, luego de sufrir graves quemaduras por la explosión de una garrafa. Este notable procedimiento se llevó a cabo en el Hospital Italiano de Buenos Aires, marcando un hito en la bioingeniería de tejidos en el país.
Innovadora Técnica de Cultivo de Piel
La revolucionaria técnica, conocida como cultivo autólogo dermo-epidérmico para autoinjerto, implica la extracción de una pequeña muestra de piel del propio paciente, que es cultivada en laboratorio para generar nueva piel. Este proceso permite reparar las áreas afectadas de manera efectiva y fue realizado en un marco médico argentino vanguardista.
El Proceso de Regeneración
La muestra fue tomada del área inguinal, midiendo 7 centímetros de largo por 2 de ancho. En un lapso de 15 días, y utilizando plasma del propio paciente para alimentar las células, se lograron crear cinco placas de piel de 9 centímetros de diámetro. En otras áreas dañadas, se aplicó piel sintética, pero se demostró que la opción natural presenta numerosas ventajas.
La Trágica Historia del Paciente
El hombre, miembro de una fuerza de seguridad, sufrió las quemaduras el día de la última gran inundación en Bahía Blanca. Intentaba escapar de las aguas subiendo a un techo cuando la garrafa explotó, causando quemaduras en el 60% de su cuerpo.
Una Alternativa Prometedora en Tratamientos
Esta nueva técnica ha sido desarrollada para optimizar la recuperación de heridas, especialmente en quemaduras severas y úlceras. Las opciones tradicionales incluían piel donada de otros individuos, piel de origen animal o materiales sintéticos, todos con sus riesgos específicos. La solución argentina propone un enfoque más seguro y natural.
Un Avance Sin Igual a Nivel Global
Los antecedentes de este tipo de procedimiento son escasos. Existen pocos estudios en Europa que han tratado con cultivos similares, pero la diferencia destacada del método argentino es su uso exclusivo de plasma, lo que reduce costos y riesgos de rechazo.
Un Trabajo en Equipo para el Éxito
Este procedimiento fue posible gracias a ocho años de investigación y el respaldo regulatorio del Incucai. Luis Mazzuoccolo, jefe de Dermatología y del equipo de Bioingeniería de Tejidos, explicó que el rápido reemplazo de la dermis es crucial para mantener la funcionalidad de la piel.
Los Cuatro Pasos de la Técnica de Cultivo
1. Extracción: Se toma una porción mínima de piel del paciente, específica para una mejor cicatrización.
2. Cultivo: La piel extraída se cultiva en plasma rico en plaquetas, que optimiza su crecimiento y disminuye riesgos de efectos adversos.
3. Autoinjerto: Después de 10 a 17 días, la piel cultivada se aplica en la herida, usando una gasa húmeda para protegerla.
4. Cierre de la Lesión: En un periodo de 30 a 120 días, se logra la regeneración natural del tejido, cuyo proceso finaliza al completar la última capa de piel.
Resultados Prometedores y Beneficios Clave
El principal objetivo de esta tecnología es reactivar la cicatrización natural de las heridas. En esta primera experiencia, la piel tratada logró recuperar su elasticidad en un 95%, un gran avance en comparación con el 75% que ofrece la piel artificial.
Este procedimiento ofrece múltiples ventajas: menor riesgo de rechazo al usar piel del propio paciente, una cicatrización más natural y estable, y una intervención mínimamente invasiva, lo que lo convierte en una opción favorable tanto a nivel estético como clínico.
Un Proyecto Multidisciplinario
El desarrollo de esta innovadora técnica involucró a profesionales de diversas especialidades, permitiendo un enfoque integral. Tras la exitosa primera operación, ya se ha llevado a cabo una segunda intervención, lo que promete aportar más datos a futuras publicaciones científicas sobre el tema.
Anahí Belatti, jefa de Abordaje Integral en Cicatrización de Heridas del Servicio de Dermatología, concluyó que este enfoque se alinea con las normas actuales sobre medicina regenerativa, ampliando las posibilidades terapéuticas para heridas crónicas y quemaduras.